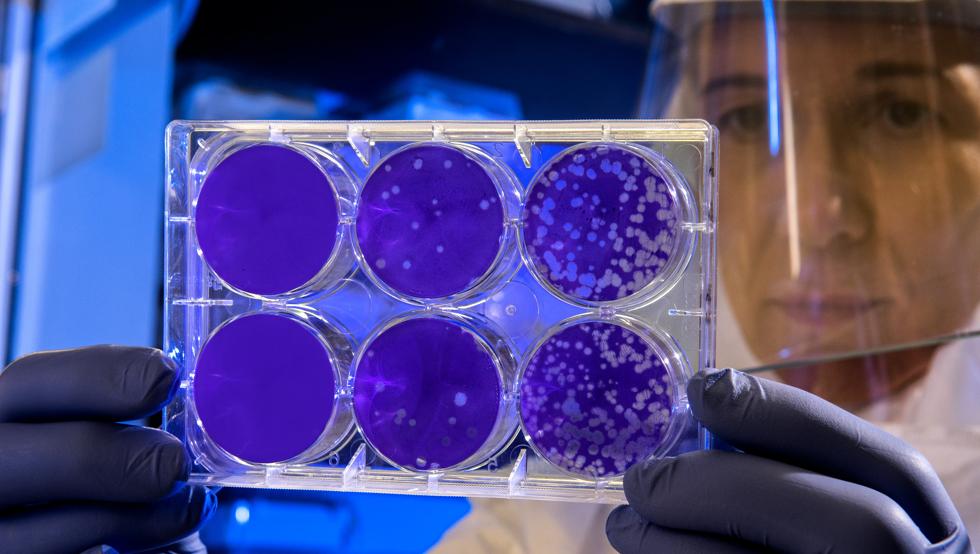

En una investigación realizada en Canadá, un grupo de científicos logró descubrir que las células cancerosas tienen la habilidad para “hibernar como los osos” con el fin de salvarse de amenazas como el tratamiento de quimioterapia.
Los resultados del estudio fueron publicados en la revista científica Cell, donde explican podrían por qué el cáncer, en sus diferentes distinciones, a menudo reaparecen después de permanecer visiblemente inactivos durante varios años tras el tratamiento, y con este nuevo resultado se espera contribuir a derrotar definitivamente la grave enfermedad.
“El tumor actúa como un organismo completo, capaz de entrar en un estado de división lenta, conservando energía para ayudarlo a sobrevivir”, explicó una de los participantes del estudio, Catherine O’Brien, cirujana en el Centro Oncológico Princess Margaret de Toronto, para el portal web científico ScienceAlert, «este estudio también nos dice cómo apuntar a estos osos durmientes para que no hibernen para despertarse y regresar más tarde, inesperadamente».
Autofagia
Experimentando con ratones, el equipo logró romper el estado de hibernación de las células cancerosas y eliminarlas para siempre con quimioterapia tras apuntar alproceso de autofagia e inhibirlo.
Ese proceso es un mecanismo biológico que consiste en que las células se comen a sí mismas para encontrar el sustento que necesitan, pero durante el estado de hibernación el cáncer lo utiliza para mantenerse con vida.
El descubrimiento de los científicos canadienses podría ser en el futuro un enfoque para abordar los tumores cancerosos que son resistentes a los tratamientos convencionales, aseguran los autores de la investigación.
Vía RT